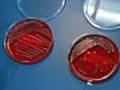
P-Seminar im Max von Pettenkofer-Institut

Newsarchiv 2010/2011 2. Halbjahr

"Mobil mit Köpfchen"
„Wir haben nur diese eine Kugel“, lautete ein sehr schlagkräftiger Satz, mit dem Herr Theobald vom ADAC die Schülerinnen und Schüler der 10. Jahrgangsstufe auf das ...
Applaus für "Alice im Wunderland"
Gar elump war der Pluckerwank! Oh je, was für ein Tag für die arme Alice (Xenia Strixner)! In der Schule wird sie wegen des Kleids gehänselt, das sie tragen muss, weil sie doch zur ...
Abiturfeier für den ersten G8-Jahrgang
Nun ist es geschafft! Die Schülerinnen und Schüler des ersten G8-Jahrgangs konnten am Montag, 04. Juli 2011, im Festsaal des Stadttheaters ihre Abiturzeugnisse in Empfang nehmen.
Neuer Schulleiter am Apian-Gymnasium ab August 2011
Mit großer Spannung wurde die Nachricht erwartet, wer nun ab August 2011 als Nachfolger von Herrn OStD Walter Schäfer das Apian-Gymnasium leiten wird. Nun ist die Entscheidung gefallen: StD ...
Apianer erreichen 3. Platz beim Stadtfinale im Beachvolleyball
Bei sommerlichen Temperaturen um die 30° C fand am 28.06.2011 auf der Beachvolleyballanlage am Baggersee das diesjährige Stadtfinale in der Wettkampfklasse II (`94 - `97) statt. Dabei ...
Stadtfinale Leichtathletik
In diesem Schuljahr konnte das Apian -Gymnasium wieder am Stadtfinale der Leichtathletik teilnehmen, nachdem im letzten Schuljahr eine Teilnahme aufgrund wiederholter Verschiebungen des Wett
P-Seminar im Max von Pettenkofer-Institut
Das Max von Pettenkofer-Institut der LMU in München beschäftigt sich mit Mikroorganismen (Bakterien und Pilzen) aus medizinischer und hygienischer Sicht.Das Ziel der Exkursion ...
APIAN-Gymnasium bekommt JUGEND FORSCHT SCHULPREIS
Bundesweit erhielten 79 Schulen für ihr besonderes Engagement die von CTS Gruppen- und Studienreisen GmbH geförderte Auszeichnung. Zu diesen Schulen gehört ...
Ökumenische MISEREOR-Aktion
Madagaskar gehört zu den Ländern mit der weltweit höchsten Analphabetenrate. Vor allem die Kinder in den abgelegenen Dörfern des Hochlands haben es schwer. Der kilometerlange Schulweg ...
Tennis Regionalfinale Jungen WK III in Gauting
Hoch motiviert machten sich unsere Tennisjungs der WK III (Jahrgang 1996 - 98) am Donnerstag, 26.5.2011, auf den Weg nach Gauting, um gegen die Jungenmannschaft ...
Tipp-Profis - Schneller mit 10 Fingern
Mit Hilfe des PC-Programms „Tippkönigin“ arbeiteten 31 Schülerinnen und Schüler der 6. und 7. Jahrgangsstufe in zwei Kursen unter der Leitung von Frau Schmette ...
Abiturfeier der Absolvia 2011 (G9)
Am Montag, 2. Mai 2011, fand die feierliche Entlassung der Abiturienten des letzten G9-Jahrgangs statt.
2. SMV-Seminar im Schuljahr 2010/11
Wie jedes Jahr fuhr die SMV des Apian-Gymnasiums zu ihrem zweiten dreitägigen Seminar vom 4. bis 6. Mai, diesmal nach Schernfeld im Landkreis Eichstätt. Dort schlugen Schüler-, Klassen,- ...
„Frühlingsgefühle“ - Nachwuchs im Vivarium
Nachdem unsere Feuersalamander-Gruppe im vergangenen Jahr ihr neues Schau-Terrarium beziehen konnte, haben wir in der letzten Zeit festgestellt, dass unser Weibchen immer „dicker“ wird.
Apian-Schülerstaffeln beim Halbmarathon
Was für ein Event!!! Und wieder unter den knapp 3000 Läuferinnen und Läufern des Halbmarathons in Ingolstadt Schülerinnen und Schüler des Apian-Gymnasium – in diesem Jahr 8 (!!!) ...